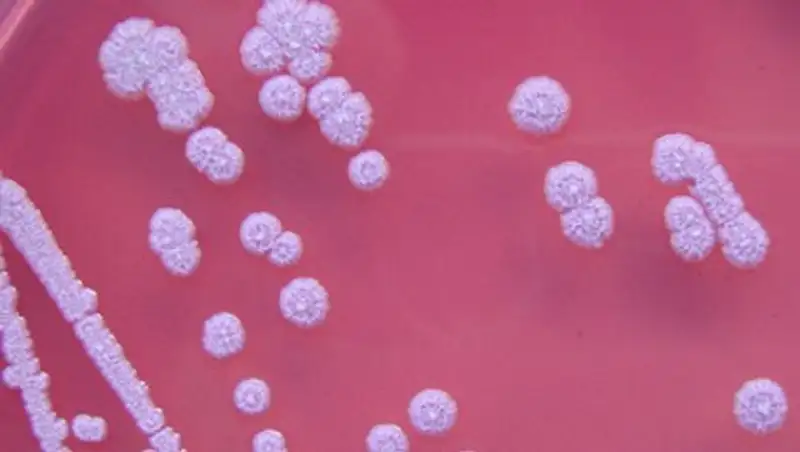
Ученые узнали о заражении смертельно опасной болезнью с одного вдоха

Музыкант плюнул в поклонницу пивом и спас ее от смертельной болезни
 @JeffreyFilman
@JeffreyFilman
Гитарист американской метал-группы Every Time I Die Джордан Бакли (Jordan Buckley) рассказал, как обрызгал фанатку пивом на концерте. Из-за боли в глазах она обратилась к врачу, что помогло своевременно обнаружить опухоль мозга. Об этом музыкант написал в своем Twitter-аккаунте.
«Ребят, хотите услышать чертову сумасшедшую историю?» — начал Бакли рассказ. Он поведал, что к нему подошла одна из поклонниц и призналась, что как-то раз была на их концерте в первых рядах, и ей в глаз попало немного пива, которое гитарист плюнул в зрителей.
На следующий день глаз болел, и она, заподозрив инфекцию, отправилась к врачу. Девушка сдала анализы и прошла осмотр. В результате врачи обнаружили, что причиной боли была опухоль мозга. Болезнь оказалась обнаружена на ранней стадии, и новообразование удалили.
По ходу рассказа музыкант постоянно извинялся и уже готовился к судебному иску. Но как только он узнал о том, что его выходка помогла диагностировать опухоль, ощутил шок.
Поклонница призналась гитаристу, что тот спас ей жизнь и поблагодарила его. «Мораль? Поход на наш концерт может спасти вам жизнь», — подытожил музыкант.